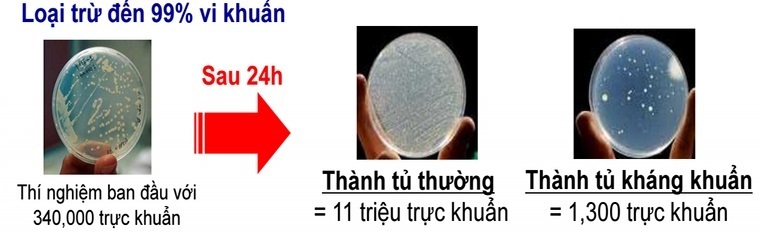
công nghệ nổi bật trên tủ lạnh mitsubishi electric

Tủ lạnh Mitsubishi Electric, là một thương hiệu tủ lạnh vô cùng quen thuộc với người tiêu dùng Việt Nam. Vậy bên trong những chiếc tủ lạnh Mitsubishi Electric này có những công nghệ gì đặc sắc? Hãy tìm hiểu qua bài viết sau.
1. Công nghệ Neuro Inverter
Được xem như "bộ não" của tủ lạnh. Công nghệ Neuro Inverter có khả năng ghi nhớ thói quen mở tủ của người tiêu dùng, từ đó đưa ra nhiệt độ làm lạnh hợp lý cũng như phân phối hơi lạnh hiệu quả, đồng thời tiết kiệm điện năng tối ưu lên đến 45% cho gia đình bạn.

2. Nhà máy Vitamin cho rau quả
Ngăn chứa rau quả của tủ lạnh Mitsubishi Electric được mệnh danh là "nhà máy Vitamin" nhờ được trang bị ánh đèn vàng cam giả lập theo ánh sáng mặt trời, giúp rau củ tiếp tục quang hợp, sản sinh ra vitamin trong quá trình bảo quản, cho rau củ luôn trong tình trạng tươi xanh như vừa mua về.

Đồng thời với nhiệt độ trong khoảng 3-9 độ C, ngăn rau củ còn lưu giữ được độ ẩm có trong rau củ lên đến mức tối đa, gúp rau củ được bảo quản trong thời gian lâu hơn.
3. Công nghệ cấp đông mềm
Ở cấp đông thường, thực phẩm bị đóng băng từ bên ngoài khiến liên kết tế bào bị phá vỡ, làm chúng mất đi các dưỡng chất và không bảo quản được lâu dài.

Nhưng với công nghệ cấp đông mềm đích thực của tủ lạnh Mitsubishi Electric, luồng hơi lạnh sẽ thổi xung quanh, giúp thực phẩm hạ nhiệt độ từ từ cả trong lẫn ngoài xuống -7 độ C mà không bị đóng băng, không phá vỡ liên kết tế bào, đảm bảo cho thực phẩm được trọn vẹn dinh dưỡng, bảo quản lâu dài lên đến 21 ngày và giúp bạn không cần tốn thời gian để rã đông trước khi nấu nướng.
4. Bộ lọc Nano Titanium
Ứng dụng chất xúc tác TiO2, bộ lọc Nano Titanium sẽ phân giải chất gây mùi thành khí carbonic và nước. Ngoài ra các vi khuẩn gây hại sẽ bị giữ lại trên lưới lọc và bị tiêu diệt hoàn toàn.

5. Thành tủ kháng khuẩn phân tử bạc
Sử dụng phân tử bạc để kháng khuẩn, chỉ trong vòng 24h mọi vi khuẩn bị ngăn chặn phát sinh và hoàn toàn bị tiêu diệt lên đến 99%, tạo môi trường sạch khuẩn cho thực phẩm được bảo quản tốt hơn.
6. Bộ lọc Carbon hoạt tính
Hệ thống khử mùi bằng bộ lọc Carbon hoạt tính ngăn chặn sự phát triển của vi khuẩn, tăng cường độ ẩm giúp bảo quản thực phẩm được lâu hơn.

7. Đệm cửa cao su kháng khuẩn
Thông thường, đệm cửa là nơi có độ ẩm cao, dễ tạo điều kiện cho vi khuẩn và nấm mốc phát sinh. Tuy vậy, với những chiếc tủ lạnh Mitsubishi Electric, đệm cửa được trang bị nam châm và tính năng kháng khuẩn bên trong, nhờ vậy tủ không chỉ được đóng sát, giữ hơi lạnh tốt mà còn hạn chế tối đa sự xuất hiện của vi khuẩn và nấm mốc gây mùi.

